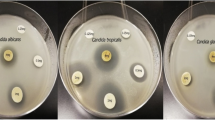

Abstract
Background
Candidiasis infection is associated with high morbidity and mortality. Fungicidal resistance of some commercially used fungicides ascended the need for a naturally effective alternative. The current study aimed to evaluate the fungicidal activity of Vitex agnus-castus extracts in vitro against some Candida species.
Methods
The bioactive compounds contained in the crude and alcoholic extracts were compared, and the antioxidant activity was tested, as well. The phytochemical analysis was carried out by Fourier Transform-Infrared Spectroscopy (FTIR) and Gas Chromatography-Mass Spectrometry (GC/MS). The scavenger activity of the tested extracts was tested, as well. The anticandidal activity was tested to detect the effect of the tested extracts on the mycelial growth of Candida albicans, Candida krusei, Candida parapsilosis, Candia tropicalis, Candida famata, Candida rhodotorula, and Candida dublinesis. The minimum inhibitory concentrations were calculated for all reported activities. The Scanning Electron Microscopy (SEM) and the Transmission Electron Microscopy (TEM) were used to detect the morphological and ultrastructure response in some selected species.
Results
FTIR and GC/MS revealed the existence of different bioactive chemical groups such as polyphenols, fatty acids, terpenes, terpenoids, steroids, aldehydes, alcohols, and esters, phytol which is a diterpene. DPPH results confirmed the antioxidant activity of all extracts where the methanolic extract was the strongest scavenging substrate. All extracts showed strong inhibitory effects against different species at a concentration of 200 µg/ml (P < 0.001). SEM and TEM showed morphological and ultrastructure changes in C. famata.
Conclusion
The current study suggested a reliable antifungal activity of different extracts of Vitex agnus-castus against different Candida species and strains. However, further studies are required to confirm the safety of these extracts to be used in medical applications.
Similar content being viewed by others

Background
For almost 5,000 years, plants were used for food, beverage preparation, and medicinal purposes [1]. Medicinal plants possess therapeutic properties or exert beneficial pharmacological effects on the human body [2]. In the Arab world, in the Middle East (excluding Iran and Turkey) and North Africa (MENA) region, medicinal plants are interesting healthcare resources and salient elements of prophetic and folk medicine [3]. Scientific studies have proven that some plants, such as garlic, pomegranate, black seeds, Costus, Miswak, Henna, ginger, and Fenugreek are effective for treating human diseases [4]. Medicinal plants enrich the sources of components that can be used in drug/ therapeutic development [2].
Medicinal plants naturally synthesize and accumulate other secondary metabolites, like alkaloids, sterols, terpenes, flavonoids, etc. [5]. Secondary plant metabolites are numerous chemical compounds produced by the plant cell through metabolic pathways derived from the primary metabolic pathways [5]. These metabolites are referred to as active substances, which have beneficial physiological effects on living organisms [6]. They possess various biological effects, which provide the scientific base of herbs in traditional medicine in many ancient communities [7]. They have been described as antibiotics, anti-fungal, and antiviral agents, and, therefore, they can protect against different pathogens [8].
Candidiasis is a common infection caused by Candida sp., widespread in the environment [9]. A characteristic phenomenon of some Candida Species is their ability to commensal with other native species of bacteria to induce harmful colonization in different organs of the human body such as the mouth, gastrointestinal tract, and vagina [10]. In one of the most frequent fungal infections, urinary tract infections (UTI), C. albicans is considered the most common source of infection, with C glabrata and C tropicalis [11]. Despite the immune response initiated to control and resist the harmful candida infection, it was reported that the excessive usage of antibiotics, which might induce morphological and genetic changes in the native bacteria increase the acidity and chemical composition of the surrounding environment and permit the candida infection [12]. The resistance to the common anti-candida treatments is a well-known issue that was reported by different medical agencies and clinical studies [13, 14]. As been reported by the Centers for Disease Control and Prevention (CDC), more than 7% of all Candida infections, particularly by C. albicans, C. parapsilosis, C. auris, and C. glabrata were resistant to fluconazole [15]. That suggested searching for other possible anti-candida treatments such as natural plant extracts.
Vitex is a member of the family Verbenaceae and includes about 250 species distributed, worldwide [16]. V. agnus-castus, commonly known as chaste tree or sage tree, is a little deciduous tree or large shrub with a showy summertime flower display [17]. V. agnus-castus fruit is commonly traditionally employed for a range of female reproductive disorders, including premenstrual syndrome (PMS) and female hormonal imbalances such as the depression, cramps, mood swings, water retention, and weight gain associated with PMS, premenstrual dysphoric disorder (PMDD), lactation difficulties, low fertility, and menopause-related complaints [18]. Several phytochemical studies showed that different parts of V. agnus-castus (fruits, leaves, and flowering stems) contain numerous secondary metabolites, such as iridoids, flavonoids, terpenoids, essential oils, ketosteroids, and vanillic acid [19]. These bioactive components are naturally occurring in most plant materials, which are known to possess interesting biological properties such as antioxidant, anti-carcinogenic, antiviral, antibacterial, anti-diabetic, and anti-inflammatory activities [20, 21]. Despite that, V. agnus-castus is poorly studied for its clinical uses.
The current study aimed to test the anticandidal effect of different extracts of V. agnus-castus leaf against different Candida species assess their possible inhibitory effects.
Materials and methods
Plant material and preparation of extracts
A new fresh, disease-free, Vitex agnus-castus plant was purchased from a local herbal market in Al Haier region, Riyadh, Saudi Arabia. Plants were identified, authenticated, and classified by Dr. Najat Bukhari, a taxonomist from the Department of Botany and Microbiology, King Saud University, Riyadh, Saudi Arabia.
For the preparation of different extracts of Vitex agnus-castus, leaves were washed several times with tap water, distilled water, and dried at room temperature. An amount of 45 g of dried leaves was crushed and grounded in 450 ml of either 96% Ethanol, absolute Methanol, or sterile distilled water to prepare the ethanolic, methanolic, or aqueous extracts, respectively. The extracts were placed in a shaker at 145 rpm for 48 h and then filtered using gauze. The filtrates were evaporated by aeration at room temperature. The dried crude extracts were rediscovered in the corresponding solvent (ethanol, methanol, or dis, water) to prepare different concentrations (25, 50, 100, 200 µg/ml). Dimethyl Sulfoxide (DMSO) was used to enhance dissolving the extract [22].
Candida strains
Eleven Candida strains were used to assess the antifungal activity of Vitex agnus-castus. The species were four strains purchased from (ATCC, Manassas, VA, United States) included C. albicans (ATCC® 60,193™), C. krusei (ATCC® 14,243™) (Ck1), C. parapsilosis (ATCC® 22,019™) (Cp1), C. tropicalis (ATCC® 66,029™). Other seven strains were obtained from either King Khalid University Hospital (KKUH), or King Abdullah International Medical Research Center (KAIMRC), Riyadh, Saudi Arabia, and included C. parapsilosis (Cp2), Candida famata, C. rhodotorula, C. dublinesis, C. auris, C. krusei (Ck2), and C. krusei (Ck3). The fresh inoculum was prepared by subculturing the studied species onto a Sabouraud dextrose agar (SDA) medium at 28 °C for 48 h, as previously described [23]. The turbidity of growing Candida suspension was adjusted to match the turbidity standard of 0.5 McFarland units, by spectrophotometry tune of 0.1 OD and was read at 600 nm wavelength.
Phytochemical analysis
Plant samples were analyzed as been described before [24].
Fourier transform infra-red spectroscopy (FT-IR) analysis
The dried powder of the aqueous extract of V. agnus-castus was used for FTIR analysis. Briefly, 10 mg of the dried extract powder was encapsulated in 100 mg of KBr pellet to prepare translucent sample discs. The powdered sample of each plant specimen was loaded in FTIR spectroscope FT-IR (Nicolet 6700 FT-IR Spectrometer, Waltham, MA, USA) [25].
Gas chromatography-mass spectrometry (GC–MS) analysis
The methanolic and ethanolic extracts were quantified by a gas chromatograph (Agilent Technologies, 7890A GC System). It was equipped with a column Agilent DB-WAX (30 m × 320 μm × 0.25 μm), coupled to a mass spectrometer Agilent Technologies (5975C V2-MSD with Triple-Axis Detector), with Autosampler and injector (G4513A) (Agilent Technologies, Santa Clara, CA, United States). The machine was programmed at temperature 60 °C for 5 min, then at 11 °C/min increments up to 250 °C. The injector flow rate was 250 °C; carrier gas was He of 99.9995% purity, column flow rate 1.2926 mL/min [25].
Determination of DPPH radical scavenging activity
A working solution of 2,2-diphenyl-1-picrylhydrazyl (DPPH) reagent at a concentration of 100 µM, was prepared as follows; by adding 4 mg of DPPH to 10 ml methanol and mixing well (Stock solution (SS) of 1 mM) and kept in dark. The methanol was diluted (1:10) and kept in darkness. A serial dilution of Ascorbic Acid (as a positive control) or tested reagents was prepared, by dilution in water and mix well (SS). The working solution (WS) (100 µg/ml) was prepared by diluting in water (1:100). In 96 well plates add the reagents (of ascorbic acid or tested reagents). Triplicates of each reagent were prepared and incubated in dark for 30 min. The absorbance was read at 517 nm [26]. The percentage inhibition of DPPH free radical scavenging activity was calculated as follows:
where:
Ac = Absorbance of DPPH (concentration 0 µg/ml).
At = Absorbance of sample (extract/ascorbic acid).
Anti-Candida bioassay and determination of minimum inhibitory concentration (MIC)
The anticandidal activity of different extracts was evaluated by the “Well Diffusion Method” [27]. Briefly, 10 mL of SDA medium was poured into the sterile Petri dishes as a basal layer, followed by the addition of 15 mL seeded medium, previously inoculated with the prepared microbial suspension at the concentration of 1 mL of fungal suspension/100 mL medium, to attain a viable cell count of 105 CFU/ml. The plates were further incubated at 35 °C for 48 h, where the inhibition zone diameter was measured using a Vernier caliper as an indication of antifungal activity. Terbinafine was used as a positive control at a concentration of 50 μg/disk. Interpretation criteria of terbinafine as the antifungal agent corresponding to the inhibition zone diameter was ≥ 20 mm.
MIC was defined as the lowest concentration of plant extract exhibiting antifungal activity. MIC was evaluated for all extracts of V. agnus-castus, as previously described [28]. MIC was calculated according to the following equation:
Detection of the morphological and ultrastructure characterizations of Candida species
Morphological and ultrastructure characterizations of selected fungal growth as a response of plant extracts detected by Scanning electron microscopy and Transmission electron microscopy.
Scanning Electron Microscope (SEM)
Primary fixation by buffered Glutaraldehyde (2.5%) overnight performed in a refrigerator, then washed by phosphate buffer (pH 7.2) and later fixed by buffered Osmium Tetroxide 1%. Then, samples were dehydrated by a series of ethanol concentrations. It then freezes dried in a critical point dryer and mounted on gold plated stubs. Samples were observed through scanning under a JEOL scanning electron microscope. The treated samples were coated with gold in a vacuum evaporator and examined with a scanning electron microscope (SEM Quanta-250, FEI, Czech Republic) [29].
Transmission electron microscopy (TEM)
Primary fixation by buffered Glutaraldehyde (2.5%) overnight performed in a refrigerator, then washed by phosphate buffer (pH 7.2) followed by secondary fixation using buffered Osmium Tetroxide 1% overnight in a 4 °C. The sample was then dehydrated by a series of ethanol concentrations and embedded by a resin mixture of SPI-Pon™- Araldite® Epoxy Embedding Kit (SPI Supplies, West Chester, PA, United States). That was followed by cutting using a Leica UC6 ultramicrotome produced section thicknesses between 70–80 nm and then loaded on a copper grid. The samples were then stained by aqua's uranyl acetate and lead citrate and examined under Jeol JSM-1011 electron microscope (Akishima, Tokyo, Japan) [29].
Statistical analysis
Means and standard deviations were calculated using IBM SPSS Statistics 22.0 (Armonk, NY, United States) [25].
Results and discussion
Phytochemical analysis of different extracts from V. agnus-castus revealed robust chemical composition
The widespread of pathogenic bacterial and fungal microbes is considered one of the problems, that threaten human existence. Several studies reported the continuous multidrug resistance, particularly, among Candida spp., which increased the efforts towards suitable substitutions. One of these efforts is the use of pump inhibitors associating drugs, such as Quinoxaline derivatives, which inhibit the activity of ATP-binding cassette (ABC) transporters, and further affected the mycelial growth of C. albicans, C. parapsilosis, C. tropicalis, C. glabrata, and C. krusei [30]. Another study showed that natural and synthetic treatment contained an adequate amount of quinolines, sulfur-containing heterocycles indoles, phenols, and pyridines can act as NorA efflux pump inhibitors, which can reduce the growth of Staphylococcus aureus [31]. In the current study, the phytochemical analysis of different extracts of V. agnus-castus showed the existence of variable phenolic compounds, which might act as efflux pump inhibitors and reduce antimicrobial resistance.
The aqueous extract of V. agnus-castus was analyzed by FTIR to investigate the functional groups (Fig. 1). The results revealed the presence of OH-stretching associated with alcohols, phenols, or polyphenols. Furthermore, the peaks revealed the existence of several functional groups Hydroxyl, aromatic compounds, amine salts, and unsaturated ketones (Table 1). In agreement with our results, a previous study showed that the FTIR analysis of V. agnus-castus proved the presence of Alkenes, alkyl halides, Aromatic compounds, phenols, and hydroxyl functional groups [32]. Another study used FTIR in the analysis of Amellia sinensis, Viola odorata, Commiphora mukul, V. agnus-castus, which revealed the presence of (C = C) stretching for a peak at 1629 and 1631 cm-1, -COOH in the range 4000–1000 cm-1, C-O and OH-stretching (carboxylic acid groups) at 1384 and 3434 cm-1, CH2-stretching at 2850 and 2922 cm-1 [33].
The results of GC/MS revealed that V. agnus-castus leaves extracts are rich in phytochemical components. A total of 34 chemical compounds were analyzed depending on the solvent type (Figs. 2 and 3). Ten compounds were investigated in the ethanolic extract (Table 2), twenty-two by methanolic extract (Table 3), and two compounds were shared in both solvents. These phytochemical compounds belong to different bioactive chemical groups such as polyphenols, fatty acids, terpenes, terpenoids, which have anticandidal activity, antioxidant, anti-inflammatory, and anticancer agents [34]. A previous study showed that plant extracts, in which Terbenoids were reported in their chemical composition, were suggested to have significant anticandidal activity [35]. Furthermore, steroids, flavonoids, phenolic acids, aldehydes, alcohols, esters, and phytol compounds were reported to have significant antiviral and antimicrobial activities [36]. In agreement with our results, a previous study showed that the extracts of V. agnus castus fruits and stems had more than 25 phenolic compounds with higher antioxidant activity such as luteolin, 3,4-dihydroxybenzoic acid, vanillic acid, chlorogenic acid, hesperidin [37]. In contrast to our findings, a previous study conducted the GC/MS analysis of V. agnus castus leaf extracts and revealed the existence of different chemical compositions included, 4,5-Dichloro-1,3-dioxolan-2-one, 1H-Indene, 2,3-dihydro-1,1,2,3,3-pentamethyl, and Isobutyl 4-hydroxybenzoate [38]. All these compounds are derivatives and constituents of different bioactive materials from middle eastern plants such as terpenes, fatty acids, steroids, polyphenols, which are known for their antimicrobial activity [39].
Antioxidants are extensively important substances that retain the capability to cover the body from damage caused by free revolutionary- convinced oxidative stress [26]. In the current study, the antioxidant activity for all V. agnus castus extracts was tested in the hunt for new bioactive composites from natural coffers (Figs. 4, 5, and 6). V. agnus castus aqueous, ethanol, and methanol extracts present the loftiest antioxidant exertion compared with reference antioxidant ascorbic acid, for DPPH scavenging exertion, attained results for DPPH agree with the phenol contents determined for each sample. The polyphenols content in different plant extracts acts as reducing agents and antioxidants by the hydrogen-giving property of their hydroxyl groups [40]. Hence, we could conclude that these polyphenols are responsible for the observed antioxidant exertion in this study.
Different extracts from V. agnus-castus showed significant anti candida activity
Different concentrations of V. agnus-castus extracts were tested to evaluate their antifungal activity against different Candida sp. (Fig. 7). As shown in Table 4, the most effective concentration in all extracts was 200 µg/ml against all species, however, the 100 µg/ml of the aqueous extract showed inhibitory effects against C. krusei and C. parapsilosis different strains. Furthermore, the growth of C. famata, C. parapsilosis (cp1), and C. parapsilosis (cp2) were significantly affected by both 100 and 200 µg/ml concentrations of ethanolic extract (P = 0.003, 0.01, 0.04) and methanolic extract (P = 0.0009, 0.02, 0.004), respectively, as compared to the anticandidal positive control (Terbinafine). The aqueous extract induced significant growth inhibition of both C. krusei (ck1) (P = 0.03) and C. krusei (ck2) (P = 0.03) with the high dose of 200 µg/ml. Also, As shown in Fig. 8, aqueous extracts showed the highest inhibitory effect on Candida growth against all species except for C. auris, C. famata, and C. rhodotorula. The growth of C. famata was strongly affected by treatment with methanolic extract, where the ethanolic extract showed the largest zone of inhibition against C. auris, C. dublinesis, and C. rhodotorula. Compared to the inhibitory effects of the Terbinafine, the aqueous extract concentration of 200 µg/ml showed higher activity against C. albicans. Also, the ethanolic extract showed higher activity against C. auris, while both methanolic and ethanolic extracts showed inhibitory effects against C. famata. All extracts had the highest inhibitory effects against C. krusei species (Table 4, Fig. 8). MIC for V. agnus-castus extracts was calculated as 150 µg/ml for most species, except for C. famata in which the MIC was calculated at 75 µg/ml (Table 4). The aqueous extract was more potent for inhibiting Candida growth than both ethanolic and methanolic extracts.
In contrast to our findings, a previous study showed that the ethanolic and methanolic extracts of V. agnus-castus L. leaves induced higher antifungal effects than the aqueous extract against Pseudomonas aeruginosa with MIC ranging from 1.56–25 µg/ml [41]. Another study showed that the concentration of 200 µg/ml of V. agnus-castus leaf different extracts had significant anticandidal activity against C. tropicalis, C. albicans, and C. ciferrii, however, the measured zones of inhibition were smaller than our results [38].
Multiple studies used different components extracted from natural plants to reduce the drug resistance observed against different pathogenic microbes. A previous study showed that the content of the essential oil extracted from V. agnus-castus L. seeds showed strong antimicrobial activity against C. albicans, C. dubliniensis, C. glabrata, C. krusei, C. parapsilosis, C. lusitaniae, C. famata, and C. tropicalis with a MIC of 130–213 µg/ml [42]. In the same manner, another study revealed that essential oil of Ruta graveolens affected the growth of C. tropicalis and C. albicans at MIC of 4.1 and 8.2 µg/mL, respectively, and that reduced the azole resistant [43]. On the cellular level, the cytocidal effects of essential oils extracted from Austroeupatorium inulaefolium revealed strong antimicrobial activity against resistant strains of Candida and bacteria at low concentrations [44]. Reportedly, other plant extracts possess antioxidant and antimicrobial properties due to the presence of phenolic compounds, such as flavonoids, hydroxybenzoic acids, and hydroxyphenyl propene [42]. Hence, V. agnus-castus might be used as a possible source of natural antifungal drugs.
To investigate the morphological and ultrastructure changes of the tested species, induced by V. agnus-castus, SEM analysis was performed against C. famata whose growth was the highest inhibited against the untreated control sample (Fig. 9). The control sample exhibited clear and well-demarcated cells that appeared with smooth walls and a defined bud morphology. The sample treated with methanolic extract showed misshapen, distorted, and damaged cell structures, revealed a swelling and rough appearance of the cell, and multiple blisters and bubbles formed on their surface (Fig. 9b). The microphotograph of C. famata showed distorted cells were flattened and had lost their normal morphology after treatment with the methanolic extract. The poor inhibitory activity of extracts against some Candida species, including C. albicans might be due to their inability to penetrate the cell membrane; some species of Candida synthesize biofilms [45]. The complex extracellular matrix of biofilm is mostly impermeable and may limit the penetration of antifungal drugs by binding to the antifungal agent and blocking target sites [45,46,47,48]. However, a previous study showed that the rich content of geraniol and linalool in some plants had a significant reduction in the number of viable biofilm cells of C. tropicalis and complete inhibition after 48 h of exposure [46]. Also, it was reported that V. agnus-castus leaves had high content of caffeic by 0.277% [49], where the Caffeic Acid Phenethyl Ester was found to inhibit the growth of different candida strains by affecting the biofilm-forming and maturation abilities, which caused their death [48]. All these studies robust the anticandidal activity of V. agnus-castus against different drug-resistant strains.
The morphological changes seen in TEM were harmonious with SEM compliances. The microphotographs of cells, that didn't admit treatment, showed clear discrimination of cell membranes and walls, complete perimeters, and well-distributed cell organelles (Fig. 10a). Still, the treated cells (200 µg/ mL of methanolic excerpt) showed dramatic structural changes in organelles, accompanied by cell wall rupture in the utmost of the observed fields, dissolution or absence of cell membranes, contracted protoplasm, blebs, bulged cell membranes, distorted, and oohing cells. Some underdeveloped cells were also observed (Fig. 10b). The antifungal exertion of methanol extracts in this study might be due to a rich excerpt with numerous phytoconstituents. Methanol is an excellent detergent that excerpts numerous polar and many nonpolar composites; phenols, glycosides, coumarins, sesquiterpenes, and alkaloids may have antifungal exertion and are anticipated to be uprooted by methanol [24].
Conclusion
Limited data is available about the medicinal uses of V. agnus-castus. More studies should be conducted to find alternative solutions, such as natural products, to control pathogens. The current study suggested that V. agnus-castus leaves extract might be used as an alternative anti-fungal treatment against Candida infections. Many phenolic and bioactive compounds were revealed, which might explain the observed anti-candida activities. More robust, randomized, controlled clinical trials would be desirable with well-characterized V. agnus-castus preparations to corroborate its beneficial effects in vivo.
Availability of data and materials
All data generated or analyzed during this study are included in this published article.
References
Dias DA, Urban S, Roessner U. A historical overview of natural products in drug discovery. Metabolites. 2012;2(2):303–36.
Sofowora A, Ogunbodede E, Onayade A. The role and place of medicinal plants in the strategies for disease prevention. Afr J Tradit Complement Altern Med. 2013;10(5):210–29.
Dehyab AS, Bakar MFA, AlOmar MK, Sabran SF. A review of medicinal plant of Middle East and North Africa (MENA) region as source in tuberculosis drug discovery. Saudi J Biol Sci. 2020;27(9):2457–78.
Aati H, El-Gamal A, Shaheen H, Kayser O. Traditional use of ethnomedicinal native plants in the Kingdom of Saudi Arabia. J Ethnobiology Ethnomedicine. 2019;15(2):1–9.
Teoh ES. Secondary Metabolites of Plants. Med Orchids Asia. 2015;5:59–73.
Erb M, Kliebenstein DJ. Plant Secondary Metabolites as Defenses, Regulators, and Primary Metabolites: The Blurred Functional Trichotomy. Plant Physiol. 2020;184(1):39–52.
Wink M. Modes of Action of Herbal Medicines and Plant Secondary Metabolites. Medicines (Basel). 2015;2(3):251–86.
Hussein RA, ElAnssary AA. Plants Secondary Metabolites: The Key Drivers of the Pharmacological Actions of Medicinal Plants. In: Builders PF, editor. Herbal Medicine. London: IntechOpen Limited; 2019. p. 11–30.
R AN, Rafiq NB. Candidiasis. [Updated 2021 Aug 13]. In: StatPearls [Internet]. Treasure Island (FL): StatPearls Publishing; 2021 Jan-. Available from: https://www.ncbi.nlm.nih.gov/books/NBK560624/
Rodríguez-Cerdeira C, Martínez-Herrera E, Carnero-Gregorio M, López-Barcenas A, Fabbrocini G, Fida M, El-Samahy M, González-Cespón JL. Pathogenesis and Clinical Relevance of Candida Biofilms in Vulvovaginal Candidiasis. Front Microbiol. 2020;11.
Behzadi P, Behzadi E, Ranjbar R. Urinary tract infections and Candida albicans. Cent European J Urol. 2015;68(1):96–101.
Mayer FL, Wilson D, Hube B. Candida albicans pathogenicity mechanisms. Virulence. 2013;4(2):119–28.
Spampinato C, Leonardi D. Candida infections, causes, targets, and resistance mechanisms: traditional and alternative antifungal agents. Biomed Res Int. 2013;2013:204237.
Pfaller MA, Diekema DJ. Epidemiology of invasive candidiasis: a persistent public health problem. Clin Microbiol Rev. 2007;20(1):133–63.
Toda M, Williams SR, Berkow EL, Farley MM, Harrison LH, Bonner L, Marceaux KM, Hollick R, Zhang AY, Schaffner W, Lockhart SR, Jackson BR, Vallabhaneni S. Population-Based Active Surveillance for Culture-Confirmed Candidemia - Four Sites, United States, 2012–2016. MMWR Surveill Summ. 2019;68(8):1–15.
Ganapaty S, Vidyadhar KN. Phytoconstituents and biological activities of Vitex - A review. J Nat Remedies. 2005;5:75–95.
Rani A, Sharma A. The genus Vitex: A review. Pharmacogn Rev. 2013;7(14):188–98.
Shaw S, Wyatt K, Campbell J, Ernst E, Thompson‐Coon J. Vitex agnus castus for premenstrual syndrome. Cochrane Database Syst Rev. 2018;2018(3):CD004632
Chen SN, Friesen JB, Webster D, Nikolic D, van Breemen RB, Wang ZJ, Fong HH, Farnsworth NR, Pauli GF. Phytoconstituents from Vitex agnus-castus fruits. Fitoterapia. 2011;82(4):528–33.
Adebayo AH, Abolaji AO, Opata TK, Adegbenro TK. Effects of ethanolic leaf extract of Chrysophyllum albidum G. on biochemical and haematological parameters of albino Wistar rats. Afr J Biotechnol. 2010;9(14):2145–50.
Teugwa CM, Mejiato PC, Zofou D, Tchinda BT, Boyom FF. Antioxidant and antidiabetic profiles of two African medicinal plants: Picralima nitida (Apocynaceae) and Sonchus oleraceus (Asteraceae). BMC Complement Altern Med. 2013;13:175.
Al-Otibi F, Albasher G, Alharbi RI, Alsaggabi NS. Antifungal Potential of Aqueous Extract of Boswellia carteri. J Pure Appl Microbiol. 2019;13(4):2375–81.
Guinea J, Peláez T, Alcalá L, Bouza E. Evaluation of Czapeck agar and Sabouraud dextrose agar for the culture of airborne Aspergillus conidia. Diagn Microbiol Infect Dis. 2005;53(4):333–4.
Rizwana H, Fatimah A, Alharbi RI, Alqusumi R. Morphology and ultrastructure of some pathogenic fungi altered by leaf extracts of senna alexandrina mill. Pak J Agric Sci. 2021;58(1):389–408.
Al-Otibi F, Alkhudhair SK, Alharbi RI, Al-Askar AA, Aljowaie RM, Al-Shehri S. The Antimicrobial Activities of Silver Nanoparticles from Aqueous Extract of Grape Seeds against Pathogenic Bacteria and Fungi. Molecules. 2021;26(19):6081.
Mahdi-Pour B, Jothy SL, Latha LY, Chen Y, Sasidharan S. Antioxidant activity of methanol extracts of different parts of Lantana camara. Asian Pac J Trop Biomed. 2012;2(12):960–5.
Kiehlbauch JA, Hannett GE, Salfinger M, Archinal W, Monserrat C, Carlyn C. Use of the National Committee for Clinical Laboratory Standards guidelines for disk diffusion susceptibility testing in New York state laboratories. J Clin Microbiol. 2000;38(9):3341–8.
Yassin MT, Al-Askar AA, Mostafa AA, El-Sheikh MA. Bioactivity of Syzygium aromaticum (L.) Merr. & L.M.Perry extracts as potential antimicrobial and anticancer agents. J King Saud Univ Sci. 2020;32(8):3273–8.
Al-Otibi F, Al-Ahaidib RA, Alharbi RI, Al-Otaibi RM, Albasher G. Antimicrobial Potential of Biosynthesized Silver Nanoparticles by Aaronsohnia factorovskyi Extract. Molecules. 2020;26(1):130.
Usai D, Donadu M, Bua A, Molicotti P, Zanetti S, Piras S, Corona P, Ibba R, Carta A. Enhancement of antimicrobial activity of pump inhibitors associating drugs. J Infect Dev Ctries. 2019;13(2):162–4.
Monteiro KLC, de Aquino TM, Mendonça Junior FJB. An Update on Staphylococcus aureus NorA Efflux Pump Inhibitors. Curr Top Med Chem. 2020;20(24):2168–85.
Abdal Sahib AH, Al-Shareefi E, Hameed IH. Detection of Bioactive Compounds of Wtex ugnus-castus and Citrus sinensis Using Fourier-transform infrared spectroscopic profile and Evaluation of Its Anti-microbial Activity. Indian J Public Health Res Dev. 201I;10(1):308–13.
Sarafraz S, Rafiee-Pour H, Khayatkashani M, Ebrahimi A. Electrochemical determination of gallic acid in Camellia sinensis, Viola odorata, Commiphora mukul, and Vitex agnus-castus by MWCNTs-COOH modified CPE. J Nanostructures. 2019;9(2):384–95.
Ghimire B, Riley WJ, Koven CD, Mu M, Randerson JT. Representing leaf and root physiological traits in CLM improves global carbon and nitrogen cycling predictions. J Adv Model Earth Syst. 2016;8:598–613.
Zore GB, Thakre AD, Jadhav S, Karuppayil SM. Terpenoids inhibit Candida albicans growth by affecting membrane integrity and arrest of cell cycle. Phytomedicine. 2011;18(13):1181–90.
Ozçelik B, Kartal M, Orhan I. Cytotoxicity, antiviral and antimicrobial activities of alkaloids, flavonoids, and phenolic acids. Pharm Biol. 2011;49(4):396–402.
Berrani A, Marmouzi I, Bouyahya A, Kharbach M, El Hamdani M, El Jemli M, Lrhorfi A, Zouarhi M, Faouzi MEA, Bengueddour R. Phenolic Compound Analysis and Pharmacological Screening of Vitex agnus-castus Functional Parts. Biomed Res Int. 2021;2021:6695311.
Ababutain IM, Alghamdi AI. In vitro anticandidal activity and gas chromatography-mass spectrometry (GC-MS) screening of Vitex agnus-castus leaf extracts. PeerJ. 2021;9.
Othman L, Sleiman A, Abdel-Massih RM. Antimicrobial Activity of Polyphenols and Alkaloids in Middle Eastern Plants. Front Microbiol. 2019;10:911.
Aberoumand A, Deokule SS. Comparison of Phenolic Compounds of Some Edible Plants of Iran and India. Pak J Nutr. 2008;7(4):582–5.
Ababutain IM, Alghamdi AI. Phytochemical analysis and antibacterial activity of Vitex agnus-castus L. Leaf extracts against clinical isolates. Asia Life Sciences. 2018;27(1):11–20.
Neveu V, Perez-Jiménez J, Vos F, Crespy V, du Chaffaut L, Mennen L, Knox C, Eisner R, Cruz J, Wishart D, Scalbert A. Phenol-Explorer: an online comprehensive database on polyphenol contents in foods. Database (Oxford). 2010;2010:bap024.
Donadu MG, Peralta-Ruiz Y, Usai D, Maggio F, Molina-Hernandez JB, Rizzo D, Bussu F, Rubino S, Zanetti S, Paparella A, Chaves-Lopez C. Colombian Essential Oil of Ruta graveolens against Nosocomial Antifungal Resistant Candida Strains. J Fungi (Basel). 2021;7(5):383.
Bua A, Usai D, Donadu MG, Delgado Ospina J, Paparella A, Chaves-Lopez C, Serio A, Rossi C, Zanetti S, Molicotti P. Austroeupatorium inulaefolium (H.B.K.) against intracellular Antimicrobial activity of and extracellular organisms. Nat Prod Res. 2018;32(23):2869–71.
Nett J, Lincoln L, Marchillo K, Massey R, Holoyda K, Hoff B, VanHandel M, Andes D. Putative role of beta-1,3 glucans in Candida albicans biofilm resistance. Antimicrob Agents Chemother. 2007;51(2):510–20.
Souza CM, Pereira Junior SA, Moraes Tda S, Damasceno JL, Amorim Mendes S, Dias HJ, Stefani R, Tavares DC, Martins CH, Crotti AE, Mendes-Giannini MJ, Pires RH. Antifungal activity of plant-derived essential oils on Candida tropicalis planktonic and biofilms cells. Med Mycol. 2016;54(5):515–23.
Desai JV, Mitchell AP, Andes DR. Fungal biofilms, drug resistance, and recurrent infection. Cold Spring Harb Perspect Med. 2014;4(10).
Alfarrayeh I, Pollák E, Czéh Á, Vida A, Das S, Papp G. Antifungal and Anti-Biofilm Effects of Caffeic Acid Phenethyl Ester on Different Candida Species. Antibiotics (Basel). 2021;10(11):1359.
Şarer E, Alper GA. Determination of caffeic and chlorogenic acids in the leaves and fruits of vitex agnus-castus. Turk J Pharm Sci. 2008;5(3):167–74.
Acknowledgements
The authors would like to extend their sincere appreciation to the Research Supporting Project number: RSP-2021/114, King Saud University, Riyadh, Saudi Arabia.
Plants classification guidelines
The plants were identified, authenticated, and classified according to the guidelines of the Department of Botany and Microbiology, King Saud University, Riyadh, Saudi Arabia, available from:https://faculty.ksu.edu.sa/sites/default/files/bot222_8_oct_2017_ali.pdf (Accessed 20th December, 2021).
Funding
This research project was supported by a grant from the Researchers Supporting Project number (RSP-2021/114), King Saud University, Riyadh, Saudi Arabia.
Author information
Authors and Affiliations
Contributions
F.A-O. contributed to the conception, study design, editing, and reviewing of the intellectual contents. F.A-O and G.A.R. were responsible for literature search, experimental applications, data acquisition and analysis, statistical analysis, and manuscript preparation. Both R.I.A. and G.A.R collected the samples and performed the experiments. F.A-O. was responsible for editing and reviewing the manuscript, besides, acting as a guarantor and corresponding author. All authors have read and agreed to the published version of the manuscript.
Corresponding author
Ethics declarations
Ethics approval and consent to participate
not applicable
Consent for publication
not applicable.
Competing interests
All authors declare no conflict of interests.
Additional information
Publisher's Note
Springer Nature remains neutral with regard to jurisdictional claims in published maps and institutional affiliations.
Rights and permissions
Open Access This article is licensed under a Creative Commons Attribution 4.0 International License, which permits use, sharing, adaptation, distribution and reproduction in any medium or format, as long as you give appropriate credit to the original author(s) and the source, provide a link to the Creative Commons licence, and indicate if changes were made. The images or other third party material in this article are included in the article's Creative Commons licence, unless indicated otherwise in a credit line to the material. If material is not included in the article's Creative Commons licence and your intended use is not permitted by statutory regulation or exceeds the permitted use, you will need to obtain permission directly from the copyright holder. To view a copy of this licence, visit http://creativecommons.org/licenses/by/4.0/. The Creative Commons Public Domain Dedication waiver (http://creativecommons.org/publicdomain/zero/1.0/) applies to the data made available in this article, unless otherwise stated in a credit line to the data.
About this article
Cite this article
Al-Otibi, F.O., Alrumaizan, G.I. & Alharbi, R.I. Evaluation of anticandidal activities and phytochemical examination of extracts prepared from Vitex agnus-castus: a possible alternative in treating candidiasis infections. BMC Complement Med Ther 22, 69 (2022). https://doi.org/10.1186/s12906-022-03552-x
Received:
Accepted:
Published:
DOI: https://doi.org/10.1186/s12906-022-03552-x